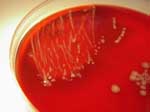
Τα βακτήρια του εντέρου «μεταμφιέζονται» ώστε να μην εντοπίζονται από το ανοσοποιητικό σύστημα

Τα γυναικεία χέρια πιο φιλόξενα για τα μικρόβια
Ουάσινγκτον: Όλοι πρέπει να πλένουν συχνά τα χέρια τους για να προστατεύονται από τα μικρόβια, όμως φαίνεται πως αυτό πρέπει να ισχύει ακόμα πιο πολύ για τις γυναίκες, αφού πάνω στις παλάμες τους υπάρχει μια πολύ μεγαλύτερη ποικιλία βακτηρίων σε σχέση με των ανδρών. Και αυτό συμβαίνει παρόλο που στατιστικά οι γυναίκες όντως πλένουν τα χέρια συχνότερα, δείχνει νέα έρευνα του Πανεπιστημίου του Κολοράντο των ΗΠΑ.

Αριθμός Πιστοποίησης Μ.Η.Τ.232442
Αριθμός Πιστοποίησης Μ.Η.Τ.232442